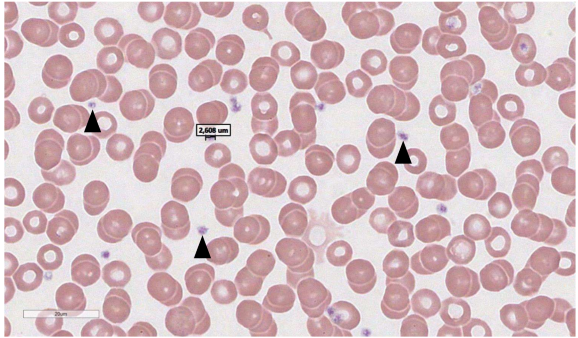
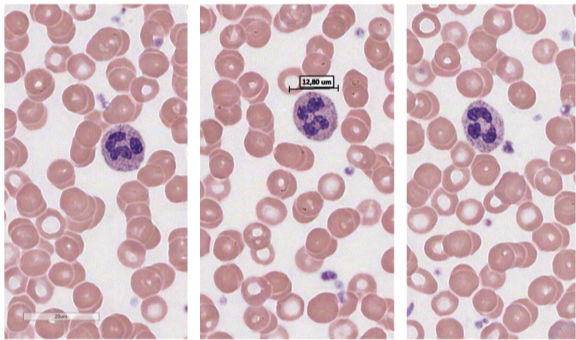
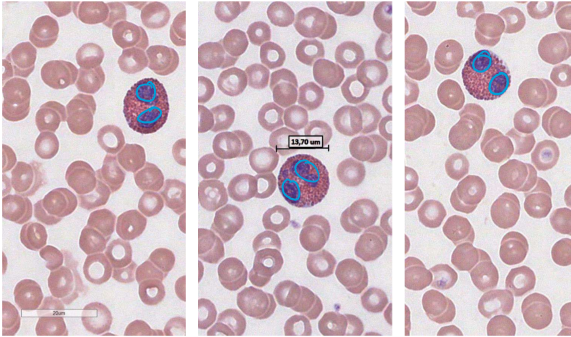
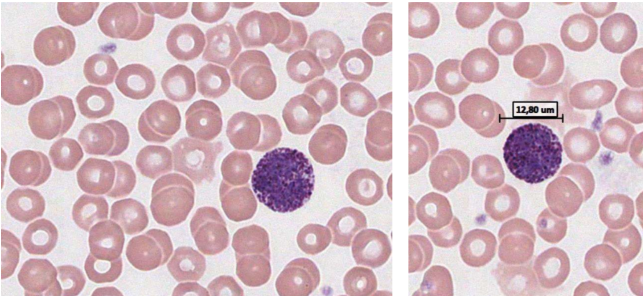
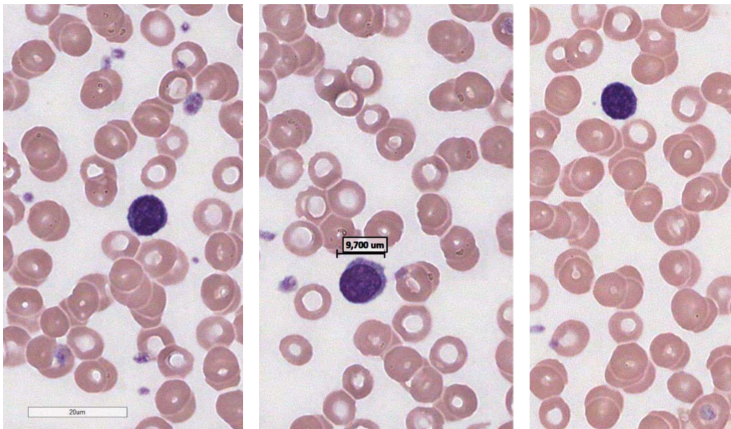
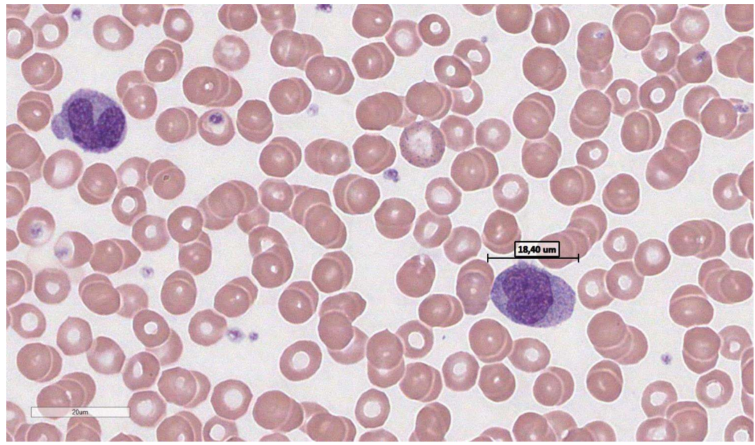

Quelle coloration on utilise pour différencier les cellules en hématologie et explique quel image représente quelle cellule et pk?

La coloration de Wright
image 1: il s’agit de basophile car bleu de méthylène colore ses granules ainsi que les acides nucléiques
image 2: il s’agit d’un neutrophile (ses grnules sont peu colorés)
image 3: il s’agit d’un oesinophile parce que ces granules sont colorés par l’eosine (plus rosé)
identifie les structures avec les flèches et les cellules en arrière plan et donne leur caractéristiques
Cellule en arrière plan : globules rouges
-pas de noyau, disque biconcave, cytoplasme homogène (sans granule)
Flèches: thrombocytes (plaquettes)
-les plus petits dans le frotti, fragments cellulaires, disque biconvexe, cytoplasme avec granules
identifie la plus grosse cellule et ses caractéristiques
Neutrophile
- 45 à 70% des leucocytes
- noyau polylobé (2à5)
- chromatine condensée (hétérochromatine)
- cytoplasme clair (on se rappelle que les granules des neutrophiles sont peu colorés )
identifie la plus grosse cellule et ses caractéristiques
éosinophile
- peu abondant (2-5% des leucocytes)
- npyau bilobé
- chromatine condensée
- cytoplasme avec granules rouges (acidophile)
identifie la plus grosse cellule et ses caractéristiques
basophile
- 0-1% des leucocytes
- noyau bilobé
- chromatine condensée
- granules violet du cytoplasme cache le noyau
identifie la cellule foncée et ses caractéristiques
Lymphocyte
- 20-40% des leucocytes
- grand noyau rond, très peu de cytoplasme
- pas de granule
- chroma condensée
identifie la plus grosse cellule et ses caractéristiques
Monocytes (futurs macrophages)
- 3à7% des leucocytes
- noyau en forme de U
- chromatine mitée (condensée et decondensée)
- cytoplasme avec lysosome


